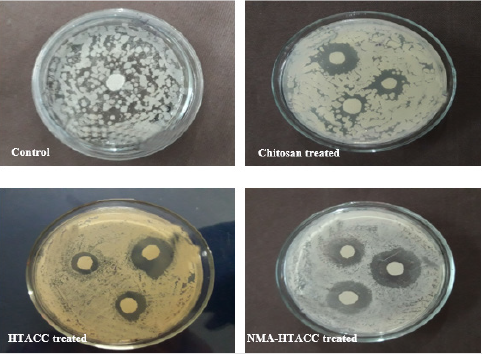
biomedres-openaccess-journal-bjstr
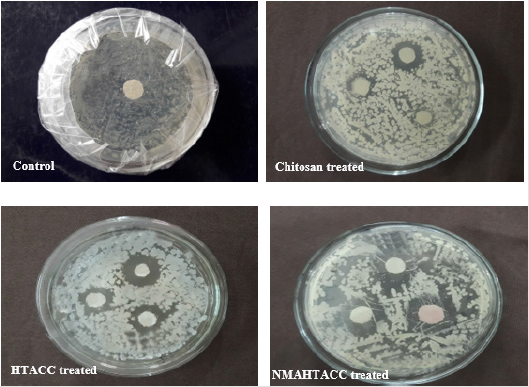
biomedres-openaccess-journal-bjstr

Abstract
The objectives of this research were to develop important properties of cotton fabric, such as antibacterial activity, moisture absorption, swelling capacity, water vapour permeability, and soil degradation by using chitosan and its water-soluble derivatives e.g., N-(2-hydroxy) propyl-3- trimethylammonium chitosan chloride (HTACC), and N-methylolacrylamide-N-(2- hydroxy) propyl-3- trimethylammonium chitosan chloride (NMA-HTACC). HTACC was synthesized from chitosan through the dispersion of chitosan with glycidyltrimethylammonium chloride (GTMAC) in aqueous medium and NMAHTACC was synthesized from the dissolution of HTACC in aqueous N-methylolacrylamide (NMA) solution in presence of NH4Cl and 4-methoxyphenol, respectively. The chitosan, HTACC and NMA-HTACC were applied on cotton fabrics by an exhaustion method and showed antibacterial activity against Escherichia coli and Staphylococcus aureus. Among all of the modifiers, NMA-HTACC showed antibacterial activity against S. aureus and E. coli at a minimum concentration of 3.3 ppm and 5.8 ppm.
The NMA-HTCC has better attachment capacity on the cotton fabric due to having hydrophilic groups and the positive charge on its structure of nitrogen atom. For this NMA-HTACC treated cotton fabric has better washing durability in water than other modifiers treated and untreated cotton fabrics and maintained over 93% of bacterial reduction against E. coli and over 94% of bacterial reduction against S. aureus even after 30 home launderings. It may also be applied to textiles to play a role in addressing hygiene and comfortable in clinical and sensitive environments by minimizing the chances for bacterial colonization of textiles and the potential for transfer from fabric surfaces.
Keywords: Cotton Fabric; Protective Medical Textiles; Chitosan Derivative; Antibacterial Activity; Modification; Swelling behaviour
Abbreviations: FTIR: Fourier Transform Infrared; SEM: Scanning Electron Microscopy ; DSC: Differential scanning calorimetry; MHB: Mueller-Hinton Broth; CLSI: Clinical and Laboratory Standards Institute; MHA: Mueller-Hinton agar; WVPT: Water Vapor Permeability Test; SEM: Scanning Electron Micrograph; MIC: Minimum Inhibition Concentration; GTMAC: Glycidyltrimethylammonium chloride; NMA: N-methylolacrylamide; NMA-HTACC: N-methylolacrylamide-N-(2- hydroxy) propyl-3- trimethylammonium chitosan chloride; HTACC: N-(2-hydroxy) propyl-3- trimethylammonium chitosan chloride
Introduction
Textiles have been considered as an indispensable part of human life science from the beginning of civilization which provides a bulk contribution in the economic growth of developing countries and finally world economy and international trade to build up sustainable development. For making the paving way for innovations, inventions and industrialization based on textiles different methods and materials are used have expanded enormously. The basement of textile is textile fibres which may either natural (cotton, jute, hemp, flax, etc.) or synthetic (nylon, polyester, acrylic, etc.) but among them, cotton is the most used textile fibre all over the world and still now its demand is increasing day by day due to some excellent properties like softness, usability, fineness, high tensile strength, good dyeability, biodegradability, biocompatibility, renewability, etc. Due to higher cellulose content, cotton fibre can retain more moisture than that of other natural fibres. This property of cotton is either good or bad depending on its end uses such as when cotton used as absorbent then it is good but when cotton used in manufacturing casual wears it’s not a good property [1].
Clothing textiles made of cotton fabric create a warm and often moist environment on the skin, which leads to the growth of bacteria which leads to the growth of microorganism (bacteria, fungi) and create unfavourable effects like unpleasant odours, staining, fabric deterioration. Not only that it also affects consumer health such as skin irritation and allergies, skin infections, etc. [2,3]. The health care market is evolving and driving the need for new technologies to protect the human body from the adverse environment. Hundred years ago, all serious sickness was handled in the hospital or the operating room in highly controlled environments for patients and workers. Today, patient care takes place in hospitals, surgery centres, nursing homes, clinics, labs, doctor’s offices and sometimes even in patient’s homes. As a result, protective medical textiles have become a very essential issue for daily life activities. Hygiene has become essential to human being way of life. This positive attitude of users towards hygiene textiles is facilitating a booming world market for a wide range of protective or specially designed textiles which is reviving the field of rigorous research and development.
Value addition in clothing has changed the global textile scenario. Research has quite convincingly shown that apparel consumers all over the world are demanding functionality in the products that they use. This Functional or Protective clothing is referred to the garments and other fabric to protect the wearer from harsh environmental effects that may result in bacterial contamination, injuries and even death [4]. Considering the consumer’s hygiene of the pathogenic microorganism, numerous anti-microbial textile products are developed using various agents like metal and their oxides, quaternary compounds, triclosan, organometallics, etc. But these are synthetic active agents with desired microbial inhibition activity. These are toxic and can create unfavourable effects on consumer health such as skin irritation, allergy and finally skin cancer. These synthetic agents also have a hazardous effect on the environment. So, for these reasons, the anti-microbial materials based on natural products are more demanded to avoid all the problems created by the synthetic anti-microbial materials [5].
Prawn and shrimp are the most important aqua-based products of Bangladesh due to their domestic and foreign demand. Bangladesh earns more than 500 million US dollar each year by exporting shrimp [6] and achieved 6th position of prawn and shrimp production in the world [7]. These are exported in frozen form, before that, they are processed according to the buyer’s requirements which generates huge amounts of waste (shell, head, tail, etc.) and make unfavourable environmental and hazardous problems [8-11]. Unfortunately, the prawn processing industries of Bangladesh are indeed disposing of their prawn processing waste by employing additional manpower [12]. Approximately 40- 50% weight of prawn or shrimp is generally lost due to processing which is estimated about 30-kilo metric tons on dry basis per year of prawn waste is disposing of in Bangladesh [12]. But this waste contains about 8-10% a valuable component known as chitin which is extensively used in various industries like pharmaceuticals, cosmetics, foods, textiles and so on [8]. Chitin can be extracted from prawn shell wastes which turn into chitosan through deacetylation.
Every year, near about a hundred tons of chitosan, is imported by the Bangladesh government for industrial purposes which market price approximately 600 million takas [13]. So, the value addition of prawn processing industrial waste is so much necessary which will reduce the present import dependency of chitosan. The utilization of waste materials to chitin and then to chitosan will fulfil the domestic demand and further will make huge foreign currency by exporting. Generally, chitosan is a copolymer of glucosamine and N-acetyl-glucosamine units linked by 1,4-glucosidic bonds and it is obtained through the alkaline hydrolysis of chitin obtained from the prawn shell waste. The unique structural feature of chitosan consists in the presence of primary amines at the C-2 position of the D-glucosamine residues and two hydroxyl functionalities. Consequently, chitosan has a polycationic nature [14]. Due to having polycationic nature, chitosan and its derivatives (e, g. HTACC and NMA-HTACC) may show antibacterial activity on cotton fabric. But the important properties such as textile strength, stiffness, shelf life, dye-ability, durability and anti-microbial efficiency etc are the issues of concern. In this research gap, intensive research should be carried out to develop antimicrobial textiles using bio-agents instead of synthetic agents [15]. The novelty of this research work is to develop bioactive textiles with specially designed chitosan derivatives i.e., HTACC and NMA-HTACC, and at the same time, an approach to highlight the economic, social and environmental impacts of prawn or shrimp processing waste’s value addition.
Experimental
Materials
Prawn shell was collected from sea fish processing area of Bagerhat, Khulna, Bangladesh. Cotton fabrics were collected from the local market, Rajshahi, Bangladesh. Escherichia coli and Staphylococcus aureus bacteria were collected from Rajshahi Laboratories of Bangladesh Council of Scientific and Industrial Research (BCSIR), Bangladesh. Hydrochloric acid (HCl), sodium hydroxide (NaOH), acetone, methanol (CH3OH) etc reagent grade chemicals were purchased.
Preparation of Quaternary Chitosan Derivatives
Extraction of Chitosan: Successive chemical treatment is required for the extraction of chitin from prawn shell waste. Before the chemical treatments, the collected raw sample (prawn shell) was thoroughly washed with hot water and dried then the sample was reduced to the desired size using an electric grinder. The chitin was extracted by three successive chemical treatments i.e., demineralization, deproteinization and decolourized [16,17]. Finally, the deacetylation reaction was carried out for the conversion of chitin to Chitosan [17,18].
Preparation of HTACC: The HTACC was synthesized by the following steps [19].
Dispersion of Chitosan: Chitosan (5 g) was dispersed in 50 mL of distilled water in a reaction vessel with constant stirring with a magnetic stirrer hot plate. After the formation of dispersion, the reaction vessel was maintained at a temperature of 85ºC by the hot plate.
Quaternization of Chitosan: Quaternization of chitosan was synthesized by adding three moles of GTMAC equivalent to one mole of the amino group of chitosan. The dispersed chitosan was treated with GTMAC where one-third of GTMAC was added initially then after 2 h interval the rest two-third was added with continuous stirring. A yellowish solution was obtained after a total 16 h reaction and the solution was transferred into 200 ml cold acetone then stored in a refrigerator for overnight. A gel-like decanted product was obtained which was dissolved in 100 ml methanol and again precipitated by adding 250 ml acetone: ethanol (4:1) mixture. The obtained filtrate was crude HTACC and it was further purified by hot ethanol washing using soxhlet extractor for 24 h.
Preparation of NMA-HTACC: NMA-HTACC was synthesized by the following steps [20-22]:
Acrylamidomethylation of HTACC: For this purpose, 1 g of HTACC was dissolved in an aqueous solution of NMA (48 wt. %) with a little amount of 4- methoxyphenol (0.2% w/v) as polymerization inhibitor at 30 °C. In the reaction media, 3 to 4 moles of excess NH4Cl was added to make the media acidic and the reaction was carried out for 8-20 min in an oil bath at 140°C. 100 ml acetone was added to the reaction media for precipitation and kept overnight. The obtained filtrate was crude NMA-HTACC. The crude NMA-HTACC was further purified by washing with acetone: ethanol mixture (1:1) and finally with ether.
Characterizations
Fourier Transform Infrared (FTIR) Spectroscopy: FTIR spectroscopic measurements were carried out in Central Science Laboratory, University of Rajshahi, Bangladesh (Model: Shimadju-8900, FTIR Spectrum, Kyoto, Japan). All the samples were dried at 105°C for 10 h and then powdered in a mortar. For FTIR, test samples were prepared by mixing and grinding a small amount of material with its 100 times dry and pure KBr. Mixing and grinding were accomplished in a mortar by a pestle. The powdered mixture was then compressed in a metal holder under a pressure to produce a pellet. The spectrum scan was taken from 400 cm-1 to 4000 cm-1 wave number.
Chitosan Liquor: Different % (w/v) of chitosan was dissolved in 2% (v/v) aqueous acetic acid solution by stirring for 2-3 h and sonicated for 2 h. The pH of the solution containing chitosan was adjusted to 5.5. To the finishing solution, 50 μL of Triton-X was added to improve the wettability [23].
HTACC and NMA-HTACC Liquor: Different % (w/v) of HTACC or NMA-HTACC was dissolved in water by stirring for 2-3 h and sonicated for 2h. To the solution, 50 μL of Triton-X was added to improve the wettability Farouk et al. [23]
Cotton Fabric Treatment
In this work, cotton fabric was treated by pad dry cure method where the fabric was dipped in the liquor of various modifier concentration and sonicated for 1 h at 70 ̊C. The fabric was dried at 100◦C for 10 min and cured at 170◦C for 5 min and again dried at room temperature [24].
Characterization of Modified Fabrics
Moisture Absorption Study: The moisture absorption study of the modified cotton fabrics, as well as washed fabric, was performed at a constant humidity level. For this purpose, both the treated and untreated fabric samples were kept in a humidity chamber. Then the moisture saturated fabric samples were analyzed by a Moisture Analyzer [25]. Moisture content is determined using the following formula:
Moisture Content (%) 
Where Ww is the weight of moisture saturated sample and Wd is the weight of the dry sample.
Swelling Behavior Study; Swelling behaviour of the modified and raw cotton fabric were determined by dripping into the water. About 1 cm2 fabric sample of known initial weight (Wi) was dipped in 100 ml distilled water at 30°C for one day. The samples were filtered, and the excess solvent was removed with the help of filter paper, then the final weight (Wf) was determined on an electronic balance. The percent swelling was calculated from the increase in initial weight in the following manner [26].
Percent Swelling (Ps) 
Where Wi is the initial weight of the fabric and Wf is the final weight of the fabric.
Water Vapor Permeability Test: This test was carried out according to ASTM E96 (procedure B) testing standard where weight loss of water through the fabric sample due to evaporation at room temperature for 24 h was measured. In this case, the fabric sample was covered over the top of water containing a cup using a cover ring. The experiment is performed in triplicate for reproducibility. The distance between water surface underside of the specimen and specimen was maintained by 10 mm. The water loss due to evaporation via fabric specimen was measured in terms of weight loss after a certain time of interval. The water vapour permeability of modified and unmodified fabric samples was determined using the following equation

Where, M is the loss in mass of water (g); T, the time interval (h); and A, the internal area of the cup (m2). A was calculated using the following relationship:

Where d is the internal diameter of the cup (mm) [27].
Soil Degradation Test: Soil burial test represents the biodegradability of a sample in terms of weight loss in a certain time interval. In this experiment, both the modified and unmodified cotton fabric were kept under soil for 4 weeks in an open place. The following equation was used to determine the biodegradation test [28].
Weight Loss (%) 
Where Wi is the initial weight of the fabric, Wt is the final weight of the fabric.
Surface Morphology: To study the surface morphology of fabric samples a Scanning Electron Microscopy (SEM) Machine (FEI Quanta Inspect, Model: S50, USA) was used. Since cotton fabrics are non-conducting, they were gold plated. Scanning was synchronized with a microscopic beam to maintain the small size over a large distance relative to the specimen. The resulting images had a great depth of the field. A remarkable three-dimensional appearance with high resolution was obtained.
Thermogravimetric Analysis (TGA/DSC): Differential Scanning Calorimetry (DSC) is an important tool to study the structural and phase changes occurring both in solid and in liquid materials during heat treatment. The principle of DSC consists of measuring heat changes associated with the physical or chemical changes occurring when any substance is gradually heated. The thermocouple (Platinum Rhodium 13%) for DSC is incorporated at the end of each of the balance beam ceramic tubes and the temperature difference between the holder in the sample and the holder on the side of the reference is detected. The signal is amplified and becomes the temperature difference signal used to measure the thermal change of the sample [29]. The thermal analyses of both treated and untreated cotton fabric samples were carried out using a thermal analyzer (PerkinElmer simultaneous thermal analyzer, STA 8000, Germany). The tests were conducted between 30 and 600 oC under an inert atmosphere (Nitrogen). The heating rate and the airflow rate were 20 oC /min and 200 ml/min respectively.
Antibacterial Test
Qualitative Tests
Inoculum Preparation: The preserved bacterial culture (E. coli and S. aureus) was inoculated on nutrient agar plates and incubated at 37oC for 24 h [30]. At least 2-3 colonies were selected from the nutrient agar plate and transferred in Mueller-Hinton Broth (MHB) using a sterile loop. Each tube of MHB containing 5 mL of media and all inoculated tubes were incubated at 370C on a shaker for 4-5 h to achieve the 0.5 McFarland standard according to the guideline of Clinical and Laboratory Standards Institute (CLSI).
Inoculation on Test Plates: With a sterile micro tip, 10 μL of inoculum was transferred to the sterile Mueller-Hinton Agar (MHA) plate. The MHA plate was inoculated with a sterile spreader by rotating the plate in 900 angle and the procedure was repeated two more times to ensure an even distribution of inoculum on the entire surface of the plate. Before applying the cotton fabric, the lid of the plate was kept open for 3-5 minutes to absorb excess surface moisture from the inoculated plate. Then both control and test cotton fabrics were gently pressed in the centre of the culture with a sterile forceps.
Quantitative Tests
Percentage Reduction Test: The samples of test material were mixed with a known concentration of bacterial suspension by continuously shaking in a shaker and the reduction of bacterial activity was measured after 18 h. Antibacterial activity of the test material was determined by comparing the reduction of the bacterial concentration of the treated and control sample which expressed as a percentage reduction after 18 h. Modified Hohenstein test was assessed based on the percentage reduction of bacteria by the test sample [31]. Percentage reduction was calculated using the following formula.

Where R is percentage reduction, A is the number of bacteria in the broth inoculated with treated test fabric sample immediately after inoculation i.e., at zero contact time and B is the number of bacteria recovered from the broth inoculated with treated test fabric sample after the desire contact period (18h) [30].
Results and Discussion
Characterization of Cotton Modifiers
FTIR Spectroscopy of Chitosan and Its Derivatives: The IR spectra of the chitin, chitosan, HTACC and NMA-HTACC are shown in Figure 1a. The FTIR spectra of chitin, chitosan, HTACC and NMAHTACC were near about same except their characteristic peaks because chitin was extracted from prawn shell and others were subsequent successive derivatives of chitin. The characteristic peaks indicated the successful conversion of chitin and its derivatives. Chitin shows two strong absorption peaks at 1660 cm-1 and 1557 cm-1 for C=O stretching and N-H bending of the secondary amide respectively (Figure 1). Whereas chitosan shows a medium and a strong peak at 1650 cm-1 1580 cm-1for N−H bending of the primary amine. In Figure 1b the spectra of the deacetylated chitosan showed a reduction of the peak at 1600 cm-1, indicating that most of the secondary amide has been further changed to a primary amine by the alkaline deacetylation. Obvious changes of the FTIR spectra are observed after quaternization of chitosan with GTMAC. In the IR spectra of HTACC, a characteristic peak at 1480 cm-1 indicates the C-H bending of tri-methyl ammonium group which was confirmed the quaternization of chitosan.
Again, N−H bending at 1626 cm-1 of the primary amine disappeared due to the change of the primary amine to the secondary aliphatic amine. A new peak at 1650 cm-1 was assigned for the C=O stretching of the secondary amide, which was a shoulder of the N−H bending peak at 1626 c m-1 as shown in Figure 1c. Besides, the spectra show a broadband at around 3400 c m-1, probably due to the increased number of hydroxyl groups. FTIR spectra of the NMA-HTACC, as shown in Figure 1d, indicates the acryl-amidomethylation did occur as the result of the peaks at 1670 and 1545 cm1. These peaks are most likely due to the C=O stretch and N–H bending of the secondary amide in the acryl-amidomethyl group, respectively.
Figure 1: FTIR spectra of prepared Chitosan and its derivatives: (a) Chitin, (b) Chitosan, (c) HTACC and (d) NMA-HTACC
Characterization Modified Cotton Fabric
Moisture Absorption Test: The moisture absorption test results are shown in Figure 2. From Figure 2, it can be seen that the rate of moisture absorption of the untreated fabric sample is lower compared to that of the treated fabric. Chitosan, HTACC, and NMA-HTACC treated cotton fabrics show more moisture absorption (%) due to the presence of hydroxyl groups (-OH) and channel-like structure. Also, for having the good attachment capacity on cotton fabric NMA-HTACC treated cotton fabric shows maximum moisture absorption (%) [25].
Swelling Test: The swelling capacity is an important test for protective medical textiles which affects the overall properties like antimicrobial activity, wound healing capacity and biomedical uses. The experimental results are shown in Figure 3. From the figure we see that untreated fabric shows the lower swelling capacity than that of treated cotton fabrics. Because treated fabrics contain more cross-linked channel structure which can retain much water for being swollen. Then the swelling capacity of NMA-HTACC modified cotton fabric is higher than others (raw, chitosan modified and HTACC modified fabric) for having not only the presence of hydrophilic groups in the film networks but also N-atom containing positive charge and higher attachment capacity as well as higher add-on percentage to the fabric [26].
Water Vapor Permeability Test (WVPT): Bolton studied a variety of dressings and determined that a WVTR (Water Vapor Transmission Rate) of about 840 g/m2/day is required to maintain a moist wound surface [32]. Water Vapor permeability occurs mainly for having different vapour pressure on both sides of the cotton fabrics. The WVP test results are shown in Figure 4. In Figure 4, the WVP of cotton fabric is high because covering of fabrics with modifiers isn’t occurred on it. But in case of treated fabrics (chitosan, HTACC, and NMA-HTACC treated), WVP was relatively decreased due to the fabric surface modification. After modification hydrophilicity as well as water retention capacity of cotton fabric was increased this ultimately decreases the evaporation rate. Among the treated fabric both the HTACC and NMA-HTACC modified cotton showed the moderate WVP whereas untreated cotton fabric showed very high and chitosan treated comparatively low WVP rate. So HTACC and NMA-HTACC modified cotton are more convenient to promote the wound healing process [33].
Soil Burial Test: From Figure 5, It can be understanding that the glycosidic linkage of cellulose of cotton fabric is easily broken down which causes comparatively fast degradation of raw cotton fabric. Whereas chitosan, HTACC and NMA-HTACC treated cotton fabric have less degradation (%) than raw fabric because of having a coating on fabric remove direct contact of soil particles with cotton fabric. From Figure 5, after 7-day weight loss (%) of raw cotton was higher than modified cotton, again weight loss (%) of NMA-HTACC modified cotton was lower among modified fabrics. Similarly, after 14, 21, and 28-day degradation of the raw and modified cotton fabric increases with increasing time. After 28-day raw fabric shows higher degradation value due to having direct contact with soil particles and NMA-HTACC treated cotton fabric shows lower degradation value due to having a covering of NMA-HTACC that helps to not come in direct contact between soil and cotton fabric [28]. Biodegradability of the cotton fabric is determined with soil burial test.
Fourier Transform Infrared (FTIR) Spectroscopy Analysis: The FTIR spectra of untreated, chitosan, HTACC and NMA-HTACC treated cotton fabrics were near about same except the additional characteristic peaks of modifiers were appeared due to modification as shown in Figure 6. All of the spectra of unmodified washed, chitosan modified, HTACC modified and NMA-HTACC modified cotton fabrics show more or less similar absorption peaks at around 1033-1060 c m-1 (C-O stretching) and 3138-3349 cm-1 (OH stretching). The FTIR spectra of chitosan modified cotton fabrics show a new peak at 1660 cm-1 which indicates the presence of C-N bonds in primary amine. The HTACC modified cotton fabrics show a new peak at 1662 cm-1 which is the evidence of N-H stretching of amine salt in modified cotton fabric. The FTIR spectra of NMAHTACC modified cotton fabrics show a new peak at 1547 cm-1 which indicates the presence of NMA-HTACC onto modified cotton fabric.
Surface Morphology: Scanning Electron Micrograph (SEM) was used to study the surface morphology of cotton fabrics. The SEM micrographs of untreated and treated cotton fabric were shown in Figure 7. Figures 7a & 7b represents SEM of unmodified cotton fabric which shows the smooth surface of cotton fabric. Due to lower solubility of chitosan, its attachment on cotton fabric appeared as few aggregated particles. HTACC and NMA-HTACC have have higher solubility, so SEM of HTACC and NMA-HTACC modified cotton fabrics shows good attachment than chitosan on cotton fabric Figures 7c & 7d.
Figure 6: FTIR spectra of cotton fabric (a) Unmodified, (b) Chitosan, (c) HTACC, and (d) NMA-HTACC modified cotton fabric.
Figure 7: Scanning electron micrograph of cotton fabric (a) Unmodified, (b) chitosan-treated, (c) HTACC-treated and (d) NMAHTACC treated cotton fabrics.
Thermal Analysis: Figure 8 shows the thermal behaviour of unmodified, chitosan modified, HTACC modified and NMAHTACC modified cotton fabrics. The thermal behaviour of cotton fabric undergoes three steps as well as weight loss such as dehydration, decomposition and char production. The initial weight loss of cotton sample at around 95 to 110 °C due to dehydration and the decomposition occurred at 295°C, 300°C, 305°C and 340°C for unmodified, chitosan, HTACC and NMA-HTACC cotton fabrics respectively. Here the weight loss is occurred due to decomposition into CO, CO2 and formation of carbonaceous char. At last, the oxidative decomposition of char has occurred which causes further weight loss. A sharp peak appeared in DSC thermogram at 375°C, 370°C, 370°C and 360°C for unmodified, chitosan, HTACC and NMAHTACC cotton fabrics respectively due to oxidative decomposition where CO and CO2 were evolved. The second exothermic peaks represent the oxidative combustion of char. From the above results, the thermal stability of modified fabrics is in the order: unmodified < Chitosan modified < HTACC modified < NMA-HTACC modified cotton fabric concerning the decomposition temperature.
Figure 8: TGA and DSC curves for cotton fabric (a) Unmodified, (b) Chitosan modified, (c) HTACC modified and (d) NMA-HTACC modified cotton fabrics.
Antibacterial Activity Measurement
Qualitative Evaluation: In this study, the cellulosic fabrics were selected for the evaluation of the relative antibacterial activity of chitosan, HTACC, and NMA-HTACC against a gram-negative bacterium (E. coli), and a gram-positive (S. aureus) in aqueous lysogenic broth by Halo method (zone of inhibition). Qualitative antibacterial activity test of different modifiers treated cotton fabric in zone of inhibition (mm) concerning the variation of concentration of modifiers against E. coli and S. aureus are represented in Figures 9 & 10 where it can be seen that the microbial zone of inhibition (mm) increases due to the increase in the concentration of modifiers but after a certain concentration zone of inhibition was remain fixed. But due to different solubility, attachment capacity on cotton fabric, presence of positive charge on the structure different modifiers have not the same antibacterial activity against both E. coli and S. aureus. Chitosan modified cotton was showed comparatively lower antibacterial activity due to its lower solubility and lower positive charge content. Whereas quaternary chitosan derivatives modified cotton fabric were showed better antibacterial activity due to their capability to cause cellular leakage and hence bacteria died [34]. On the other hand, these quaternary derivatives were highly soluble in water which also responsible for higher antibacterial activity (Figures 11 & 12).
Determination of Minimum Inhibition Concentration (MIC) of Modified Cotton Fabric against Both E. coli and S. aureus
Again NMA-HTACC has nearly the same antibacterial activity mechanism but for being most soluble and attachable on the cotton fabric it has more antibacterial activity. Among of all the modifiers NMA-HTACC treated cotton fabric shows the highest antibacterial activity. The least concentration of antimicrobial agent at which the growth of bacteria is inhibited successfully is known as Minimum Inhibition Concentration (MIC). Due to different structure, different modifiers have variation in antibacterial activity. From Figures 13 & 14, variation in antibacterial activity of chitosan, HTACC, and NMA-HTACC is observed. From Figures 13 & 14, it can be seen that NMA-HTACC treated cotton fabric shows antibacterial activity at lower concentration (MIC= 5.8mg/L and 3.3mg/L against E. coli and S. aureus respectively) than any other modifiers treated cotton fabrics due to having more bacteria active positive charge content and high reactivity to cellulosic cotton fabric.
Figure 13: Minimum Inhibition Concentration determination of modified cotton fabric against E. coli.
Figure 14: Minimum Inhibition Concentration determination of modified cotton fabric against S. aureus.
Quantitative Evaluation: The inoculation test method was used for quantitative assessment where two chosen bacteria i.e., E. coli (gram-negative) and S. aureus (gram-positive) at 8.42x107 (colony-forming units) CFU/mL and 5.26x107 (colony-forming units) CFU/mL respectively were used in nutrient broth [30].
Determination of the Bacterial Reduction (%) Modified Cotton Fabrics against Both E. coli and S. aureus
From the above Figures 15 & 16, modified cotton fabric showed excellent antimicrobial activity for both gram-positive (S. aureus) and gram-negative (E. coli) bacteria. Here both bacteria have negative charge on their outer surface which is responsible to be neutralized with the positive charge of chitosan, HTACC, and NMA-HTACC.
Chitosan normally has no positive charge on its structure but in acidic medium by protonization positive charge is created on its structure. Below pH 6 it has a positive charge. Chitosan has the value of bacterial reduction (%) is 88.6% for S. aureus and 86.1% for E. coli. HTACC produced after quaternization of chitosan has good solubility in acidic and basic conditions due to having positive charge containing a nitrogen atom. Also, for having a positive charge and its higher solubility it shows more antibacterial activity against E. coli and S. aureus. For this, it has more bacterial reduction activities (95.4% for S. aureus and 91.7% for E. coli) than chitosan. Due to the similar antimicrobial mechanism like HTACC modified cotton, NMA-HTACC modified cotton fabric showed excellent antimicrobial activity and it was higher than those of chitosan and HTACC modification. Because NMA-HTACC showed higher add-on percentage on cotton fabric. For this NMA-HTACC has comparatively more antibacterial activity than both chitosan and HTACC. The values of percentage of bacterial reduction of NMAHTACC treated cotton fabric are 97.8% for S. aureus and 93.7% for E. coli which are higher than the other two.
Washing Durability measurement
Figures 17 & 18 represent the relationship between treated cotton fabric laundry wash and antimicrobial activity. In these figures, different modified cotton fabrics show different bacterial reduction (%) against E. coli and S. aureus. Figures 17 & 18 show that chitosan treated cotton fabric has much lower bacterial reduction (%) after 30 launderings comparatively than other modifiers treated cotton fabrics. This poor wash durability of chitosan treated fabric is the result of poor bonding between chitosan and cellulose of cotton. That’s why; chitosan cannot be recommended as durable antibacterial finishing agent but can be used in nonwashable cotton fabric. On the other hand, from Figures 17 & 18, it is also obtained that HTACC and NMA-HTACC treated cotton fabrics show bacterial reduction above 85% up to 30 laundry wash. A strong hydrogen bond was formed between quaternary chitosan derivatives (HTACC and NMA-HTACC) and cellulose of cotton fabric. At the same time, Van-der Waals Force existed between them which is also responsible for strong fixation [35].
Conclusion
In this study cotton fabric is treated with chitosan as a natural modifier to improve the properties of antibacterial activity, moisture absorption, swelling capacity, water vapour permeability, and soil degradation. Chitosan possesses strong antibacterial activity. However, to some extent, applications of chitosan are limited due to its high viscosity and low solubility. To overcome the drawbacks of chitosan, two water-soluble chitosan derivatives such as HTACC (by quaternization of chitosan) and NMA-HTACC (by acryl-amidomethylation of HTACC) are prepared. The conversion of chitosan to HTACC and NMA-HTACC are characterized by FTIR analysis. Chemical method was used for cotton fabric modifications. All the modifiers improve antibacterial properties and other textile properties of cotton fabric. But NMA-HTACC treated cotton fabrics show the highest antibacterial activities. At 1% concentration of NMA-HTACC treated cotton fabrics show bacterial reduction 93.4% against E. coli (8.42×107 CFU/mL) and 94.5% against S. aureus (5.26×107 CFU/mL) after 30 laundering cycles. Finally, it can be concluded that as NMA-HTACC treated cotton fabric exhibited better textile performance with excellent broad-spectrum antimicrobial activity in a wide range of laundry washing, it can be a good ecofriendly antimicrobial finishing agent for textile industries for designing protective medical textiles.
Acknowledgement
The authors would like to acknowledge the Faculty of Engineering, Rajshahi University, Bangladesh for funding the Project Ref. No.: 1043/5/52/RU/Eng/2/18-19/83.
References
- Morais DS, Guedes RM, Lopes MA (2016) Antimicrobial Approaches for Textiles: From Research to Market. Materials 9(6): 498.
- Qian L, Sun G (2003) Durable and Regenerable Antimicrobial Textiles: Synthesis and Applications of 3-Methylol-2,2,5,5-tetramethylimidazolidin-4-one (MTMIO). Journal of Applied Polymer Science 89: 2418-2425.
- Szostak Kotowa J (2004) Biodeterioration of textiles. International Biodeterioration and Biodegradation 53: 165-170.
- Kavitha K, Rynghang SJ, Peter DJ (2017) Antimicrobial activity of sea weed - Ulva lactuca against common bacterial pathogens, Staphylococcus aureus and Escherichia coli. Indian Journal of Applied Microbiology: 20(1): 42-46.
- Simoncic B, Tomsic B (2010) Structures of Novel Antimicrobial Agents for Textiles – A Review. Textile Research Journal 80(14): 1-17.
- BFFEA (2017) Shrimp and Fish News: Newsletter of Bangladesh Frozen Foods Exporters Association (BFFEA). April-June, 2017, BFFEA, Dhaka, Bangladesh p. 2-41.
- Rahman MM, Hossain MM (2009) Production and Export of Shrimp of Bangladesh: Problems and Prospects. Progressive Agriculture 20(1-2): 163-171.
- Kandra P, Challa MM, Jyothi HKP (2011). Efficient use of shrimp waste: present and future trends. Applied Microbiology and Biotechnology 93(1): 17-29.
- Suparno, Poernomo A (1992) Fish waste utilization in Indonesia. Asian Food Journal 7(2): 67- 72.
- Irianto HE, Giyatmi J (1997) Post-harvest technology of shrimp: Review of Indonesian experience. Aquatic Food Product Technology 6: 5-20.
- Khan M, Nowsad A (2013) Development of protein enriched shrimp crackers from shrimp shell Wastes. Journal of the Bangladesh Agricultural University 10(2): 367-374.
- Nowsad A (2005) Post-harvest Loss Reduction in Fisheries in Bangladesh: A Way Forward to Food Security Food and Agriculture Organization of the United Nations, Dhaka, Bangladesh, p. 77.
- Slam SZ, Khan M, Nowsad A (2016) Production of chitin and chitosan from shrimp shell wastes. Journal of Bangladesh Agricultural University 14(2): 253-259.
- Kong M, Chen XG, Xing K, Park HJ (2010) Antimicrobial properties of chitosan and mode of action: A state of the art review. International Journal of Food Microbiology 144: 51-63.
- Joshi M, Ali SW, Purwar R, Rajendran S (2009) Ecofriendly antimicrobial finishing of textiles using bioactive agents based on natural products. Indian Journal of Fibre and Textile Research 34(3): 295-304.
- Alam R, Khan MA, Khan RA, Ghosal S, Mondal MIH, et al. (2008) Study on the physic-mechanical properties of photo-cured chitosan films with oligomer and acrylate monomer. Journal of Polymers and Environment 16: 213-219.
- George EFR (2009) Thirty years of progress in chitin and chitosan, Progress on chemistry and application of chitin and its derivatives, Bioengineering Research Unit, Nottinghum University, England 3: 7-17.
- Islam M, Mondal MIH, Hoque A (2015) Synthesis of chitosan derivative for an eco-friendly cotton fibre modifier with enhanced physico-chemical characteristics. In: Mondal MIH. editor, Cellulose and Cellulose Composites, Nova Science Publishers, Inc., New York, 4: 81-98.
- Lang GH, Wendel, Konard E (1990) Process for making quaternary chitosan derivatives for cosmetic agents. US Patent 4: 921-949.
- Kim YH, Choi HM, Yoon JH (1998) Synthesis of a quaternary ammonium derivative of chitosan and its application to a cotton antimicrobial finish. Textile Research Journal 68(6): 428-434.
- Yoo DI, Shin YK, Kim J (1997) Functional finishing of cotton fabrics by treatment with chitosan, in: Advances in Chitin Science. Jacques André Publisher 2: 763-770.
- Park WH, Lee KY, Choi JH, Ha WS, Chang BH, et al. (1996) Characterization of chitosan-treated wool fabric (I) – Antimicrobial and deodorant activities. Journal of Korean Fiber Society 33(10): 855-860.
- Farouk A, Moussa S, Ulbricht M, Textor T (2012) ZnO Nanoparticles-Chitosan Composite as Antibacterial Finish for Textiles. International Journal of Carbohydrate Chemistry 693629: 8.
- AbdElhady MM (2012) Preparation and Characterization of Chitosan/Zinc Oxide Nanoparticles for Imparting Antimicrobial and UV Protection to Cotton Fabric. International Journal of Carbohydrate Chemistry 840591: 6.
- Abbasipour M, Mirjalili M, Khajavi R, Majidi MM (2014) Coated Cotton Gauze with Ag/ZnO/chitosan Nanocomposite as a Modern Wound Dressing. Journal of Engineered Fibers and Fabrics 9(1): 124-130.
- Vimala K, Mohan YM, Varaprasad K, Redd NN, Ravindra S, et al. (2011) Fabrication of Curcumin Encapsulated Chitosan-PVA Silver Nanocomposite Films for Improved Antimicrobial Activity, Journal of Biomaterials and Nano-biotechnology 2(1): 55-64.
- Das S, Kothari VK (2012) Moisture Vapor Transmission Behaviour of Cotton Fabrics. Indian Journal of Fibre and Textile Research 37: 151-156.
- Hassan MM, Islam MR, Khan MA (2002) Evaluation of dye treated jute textile reinforced polypropylene composites. Journal of Polymers and the Environment 10(4): 126-134.
- Serkan KOL (2007) Comparative adsorption studies of heavy metal ions of chitin and chitosan biopolymers. M.Sc. thesis, the Graduate School of Engineering and Science of Azmir Institute of Technology p. 14-15.
- Rajendran R, Balakumar C, Ahammed HAM, Jayakumar S, Vaideki K, et al. (2010) Use of zinc oxide nano particles for production of antimicrobial textiles. International Journal of Engineering, Science and Technology 2(1): 202-208.
- Syamili E, Elayarajah B, Kulanthaivelu R, Rajendran R, Venkatrajah B, et al. (2012) Antibacterial Cotton Finish Using Green Tea Leaf Extracts Interacted with Copper. Asian Journal of Textile 2(1): 6-16.
- Bolton LL, Monte K, Pirone LA (2000) Moisture and healing: beyond the jargon. Ostomy Wound Manage 46: 51S-62S, quiz 63S-64S.
- Nawalakhe R, Shi Q, Vitchuli N, Noar J, Caldwell JM, et al. (2013) Novel Atmospheric Plasma Enhanced Chitosan Nanofiber/Gauze Composite Wound Dressings. Journal of Applied Polymer Science 129(2): 916-923.
- Sudardshan NR, Hoover DG, Knorr D (1992) Antibacterial action of chitosan. Food Biotechnology 6(3): 257-272.
- Lim SH, Hudson SM (2004) Comparison and Characterization of Regenerated Chitosan from 1-Butyl-3-methylimidazolium Chloride and Chitosan from Crab Shells. Carbohydrate Polymers 56: 227-234.
Research Article